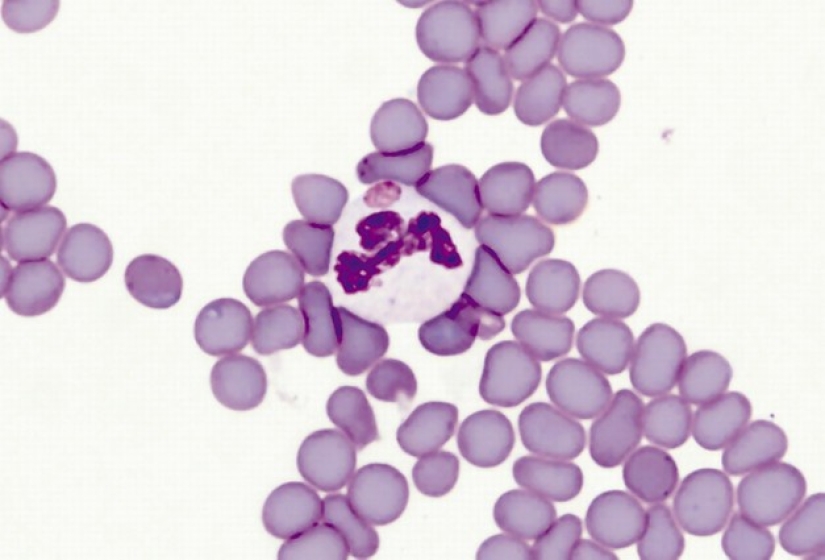
Summer literacy: what you get from the arthropods on a normal walk

Summer literacy: what you get from the arthropods on a normal walk
Categories: Health and Medicine
By Pictolic https://pictolic.com/article/summer-literacy-what-you-get-from-the-arthropods-on-a-normal-walk.html"James, don't touch the cat, you'll catch something nasty" is a phrase we hear regularly. But with the caveats concerning the small flying and crawling creatures in our latitudes have to face infrequently. We are confident that the threat of diseases carried by arthropods — a lot of warm countries, but doctors do not think so. We will tell you about the five dangerous infections that can reward us domestic biting, stinging and blood-sucking creatures.

Luckily, our mosquitoes conditionally can be considered safe. In addition to itchy blisters no problem they deliver we can't. Theoretically, in the southern regions, probably malaria, but in recent years, thanks to extensive preventive measures, such cases are rare. But mites can seriously undermine the health, and sometimes even threaten life.
These two diseases people are rewarded mites. Their symptoms are very similar, but the incubation period is about two weeks. Symptoms appear suddenly is a headache, fever, cough, nausea, abdominal pain and even, sometimes, confusion.
In some cases, often with erlihioza in children, the body can appear itchy rash. The disease is hard, but fortunately, almost always ends in complete recovery. Still good in these infections a little as a painful condition permanently unsettling, and drugs for the treatment is quite expensive.

Another disease pathogens which are transmitted to humans by the bite of ticks. The initial stage of the disease is very similar to the flu but then the symptoms increase like a snowball — there is an ache in the joints, shooting pains in the extremities, abnormal heart rhythm and paralysis of the face.
To distinguish Lyme disease from SARS can be red rash in the form of dots arranged in a circle. This infection is insidious and if left untreated, it may lead to inflammation of the brain or spinal cord. The consequences of such complications, as a rule, very sad. The person may remain disabled and even die.

To tularemia can also be from the mites, not only a field or forest, but also from those that live on dogs and cats. Sometimes carry fleas, and rarely flies. In the site of the bite where the infection has entered the body, there is ulcer. Later, a fever and enlarged lymph nodes, starts sweating and severe weakness.
Tularemia can go in the pulmonary form and cause pneumonia. This is the most severe course of the disease, which may be complicated by lung abscess. Neglected, the disease threatens not only health but also human life. Fortunately, modern medicine is fast to cope with this disease, of course, if the patient applied in time.

Babesiosis is infection of red blood cells of our blood. The vectors of the disease — pasture mites, and the intermediate "masters" of microorganisms can be cattle and dogs. The danger of this disease is that it has a destructive impact on the red blood cells, but may not have obvious symptoms.
Neglected babesiosis can manifest as jaundice, accompanied by severe fever. A particularly dangerous disease because it can cause hemolytic anemia, a condition dangerous to human life.

The title of this infection is becoming clear that the blame again clamp. The disease is very similar to the flu but is much heavier. The name "recurrent" suggests that the symptoms may disappear and then suddenly come back and so countless times.
Often carry bacteria of this type is ticks, not remaining at the bite site. They drink blood and unattached from the body so to ignore this threat attack is not easy. But if a few days after a summer hike in the woods or in the field temperature rose, began runny nose, cough and aching joints, it is better to go to the hospital and get tested. Timely treatment quickly eradicate this infection.
Sometimes, in order to deal with small vectors do not even need to go far — they could take us home and, moreover, directly in bed.
Keywords: The disease | Doctors | Infection | Mites | Forest | Danger | Field | Symptoms
Post News ArticleRecent articles
American Alex Greenberg, who moved to China, collects funny and brain-bearing examples of Chinese fashion in his Shanghai Observed ...
New Year is a holiday of magic and fulfillment of wishes. Naturally, I want this holiday to be remembered for a long time and to be ...
Related articles
We all know that allergies can be cats, dogs, chocolate, citrus fruits and pollen. But things that can cause a dangerous reaction, ...
Relatively recently, the world began to learn about gender diversity. Started talking about a lot of things that have never been ...
Because of the coronavirus pandemic, many of us feel tired and irritated. And if fatigue occurs due to stress and lack of sleep, ...

In a recent issue of sexual harassment on everyone's lips. Inappropriate and Intrusive signs of attention began to see around, even ...